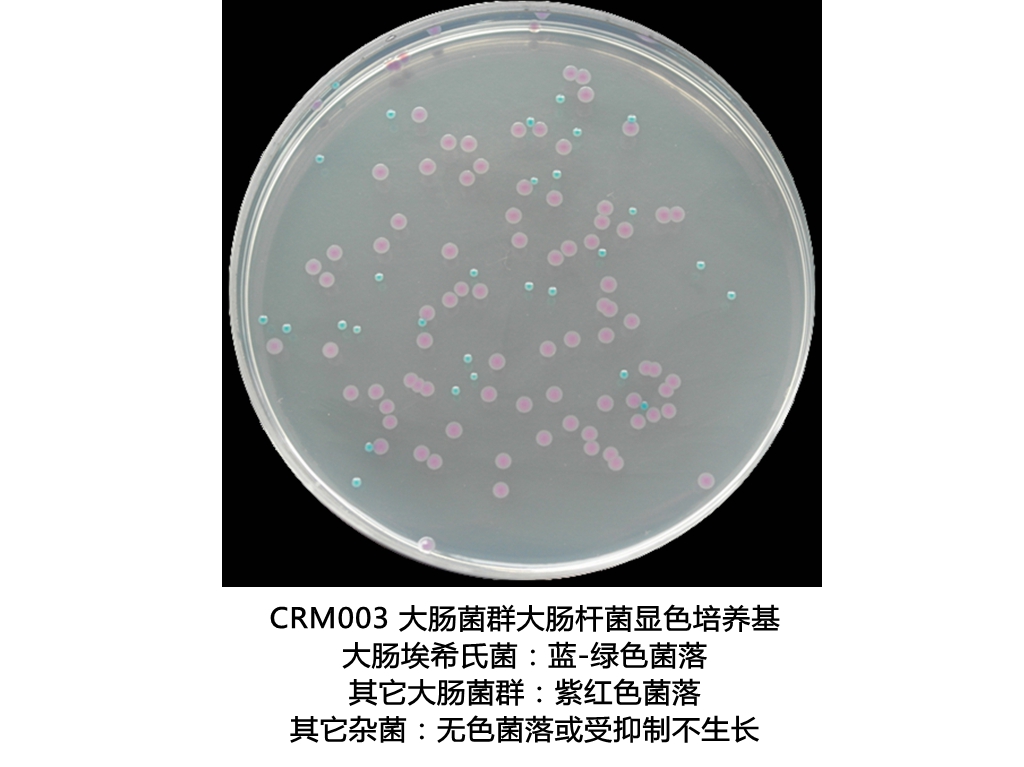
大肠菌群显色培养基
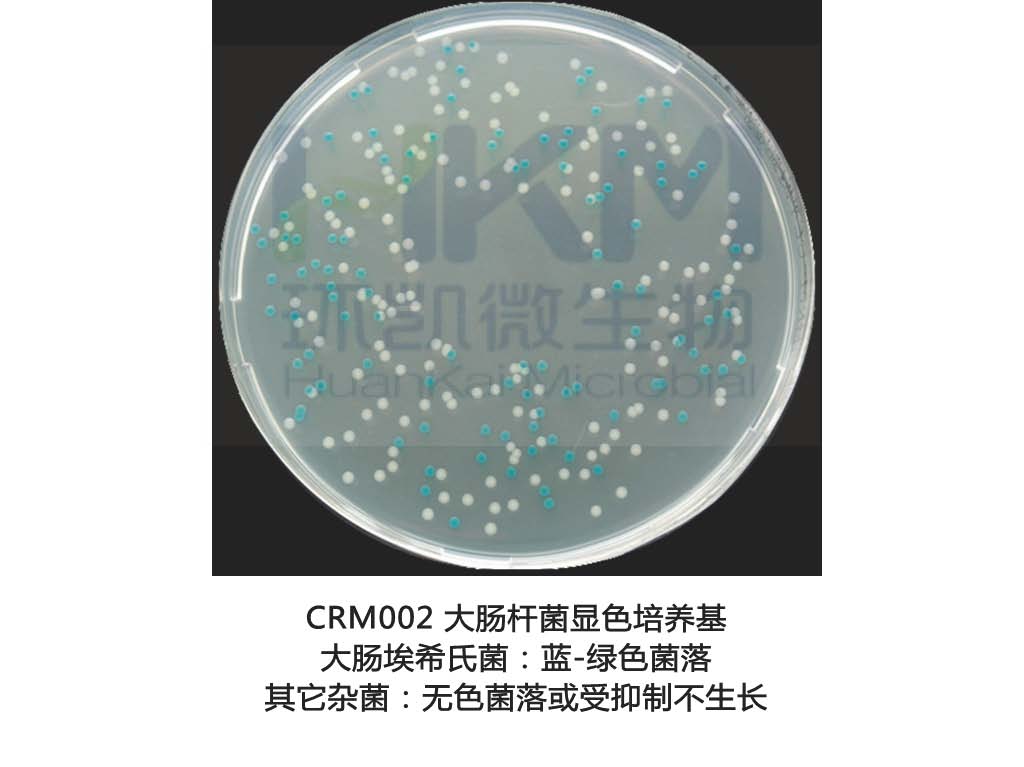
大肠杆菌显色培养基
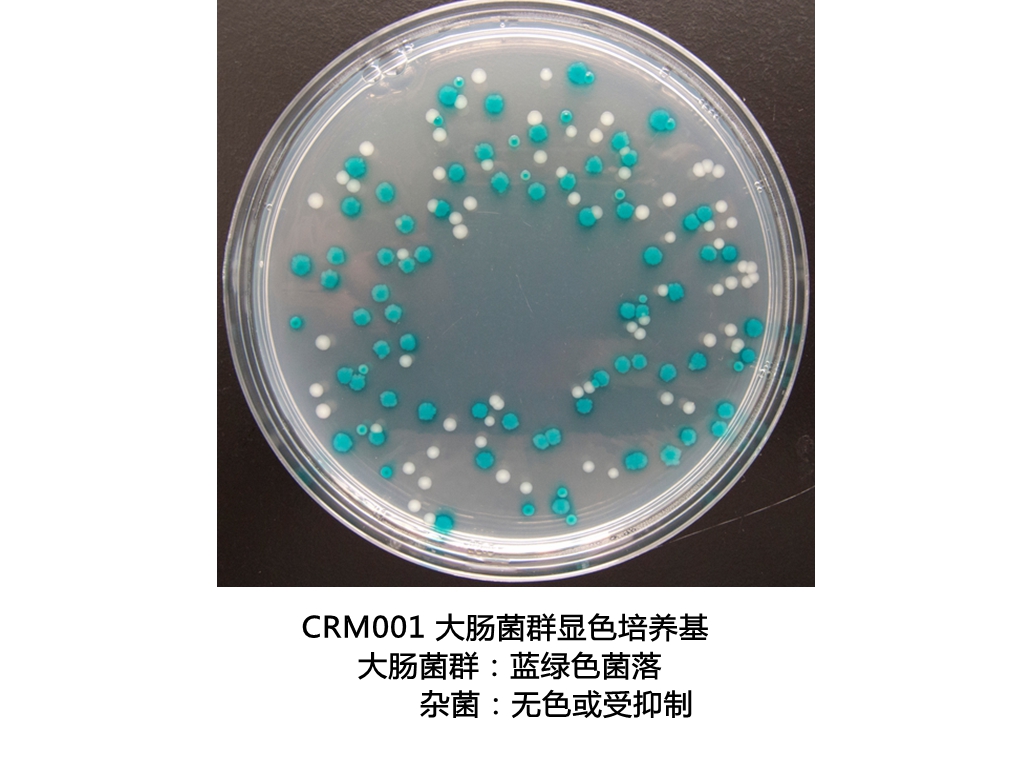
大肠菌群大肠杆菌显色培养基
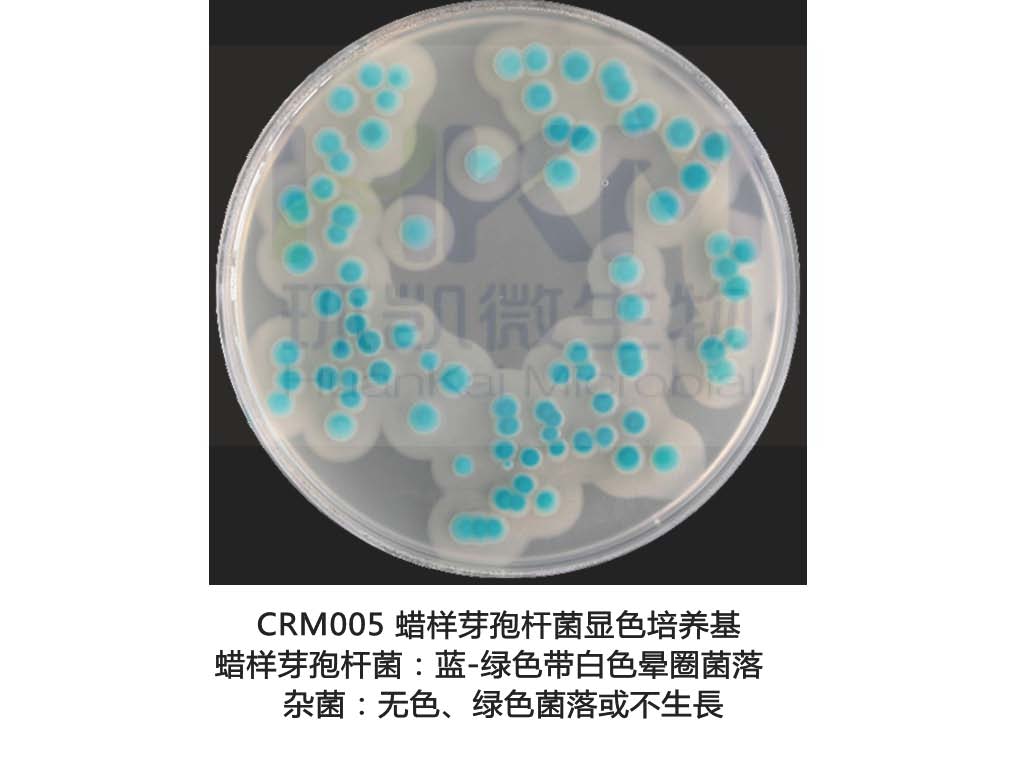
蜡樣(yàng)芽孢杆菌第二代显色培养基
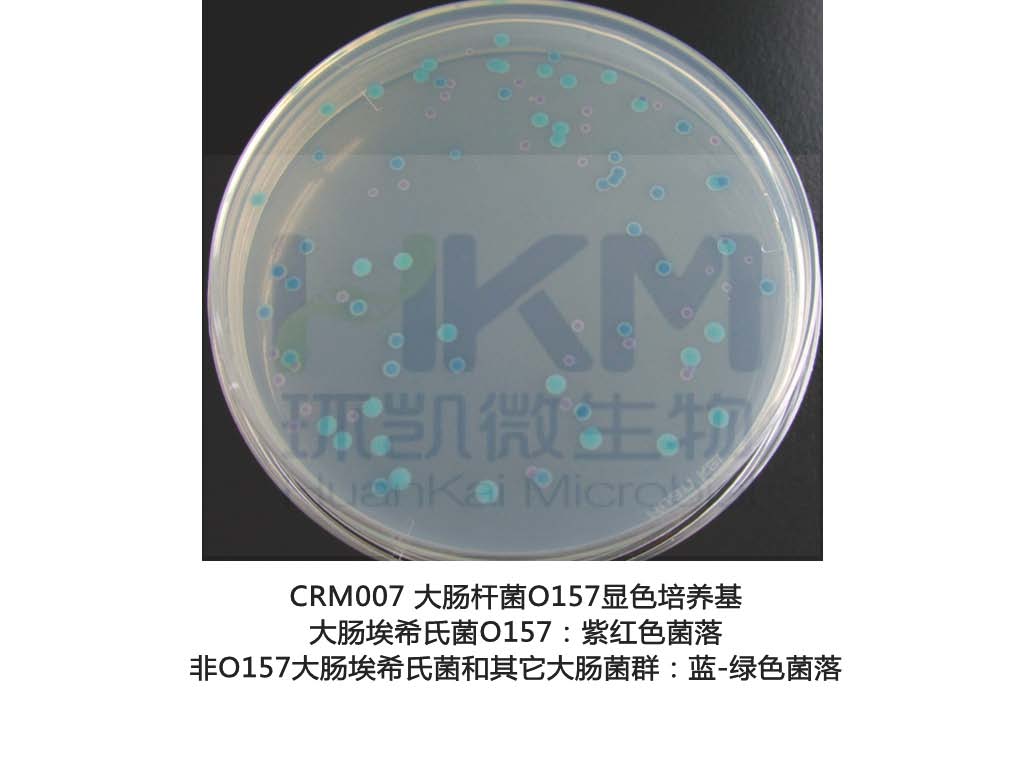
大肠杆菌O157显色培养基
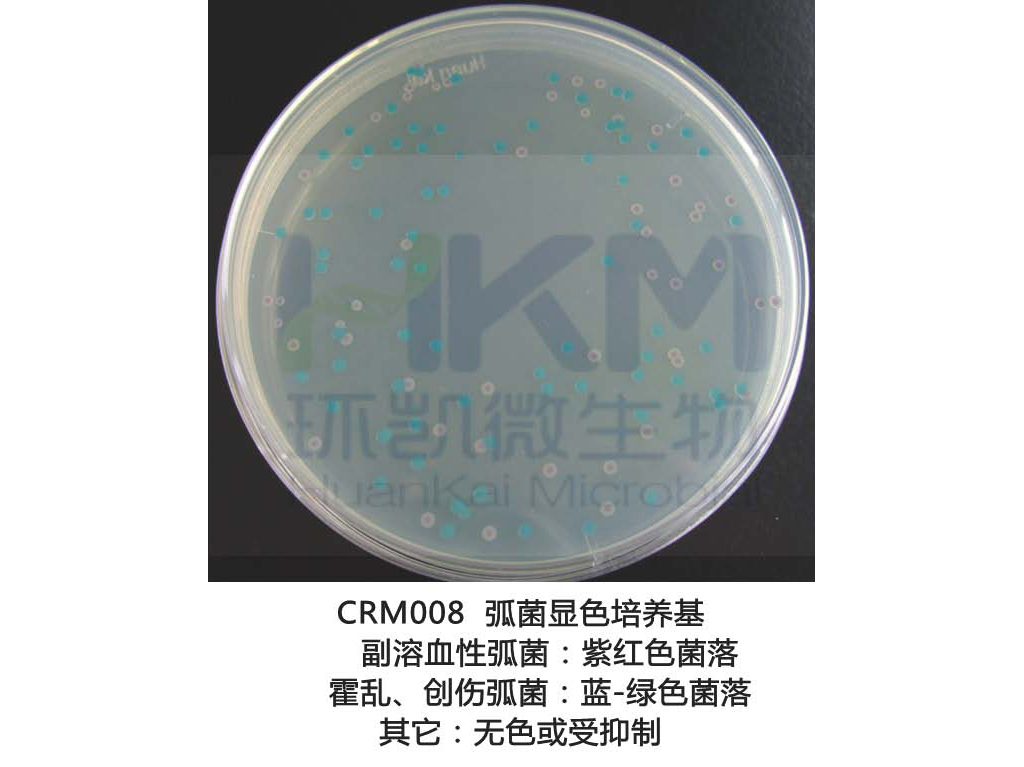
弧菌显色培养基
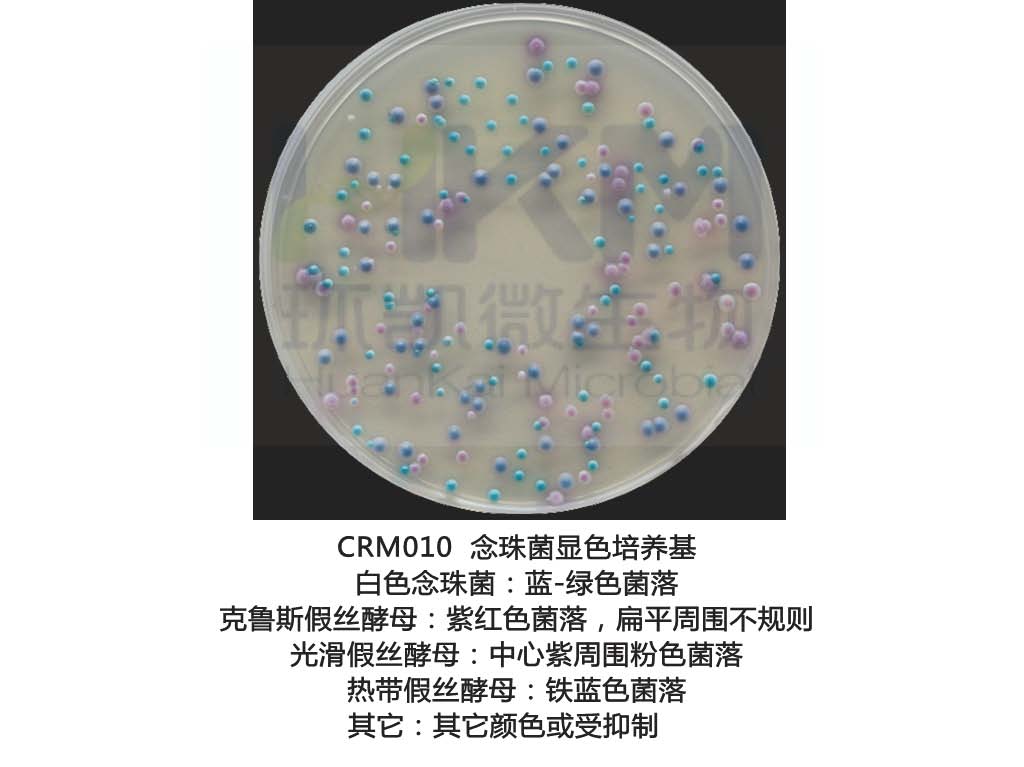
念珠苗显色培养基
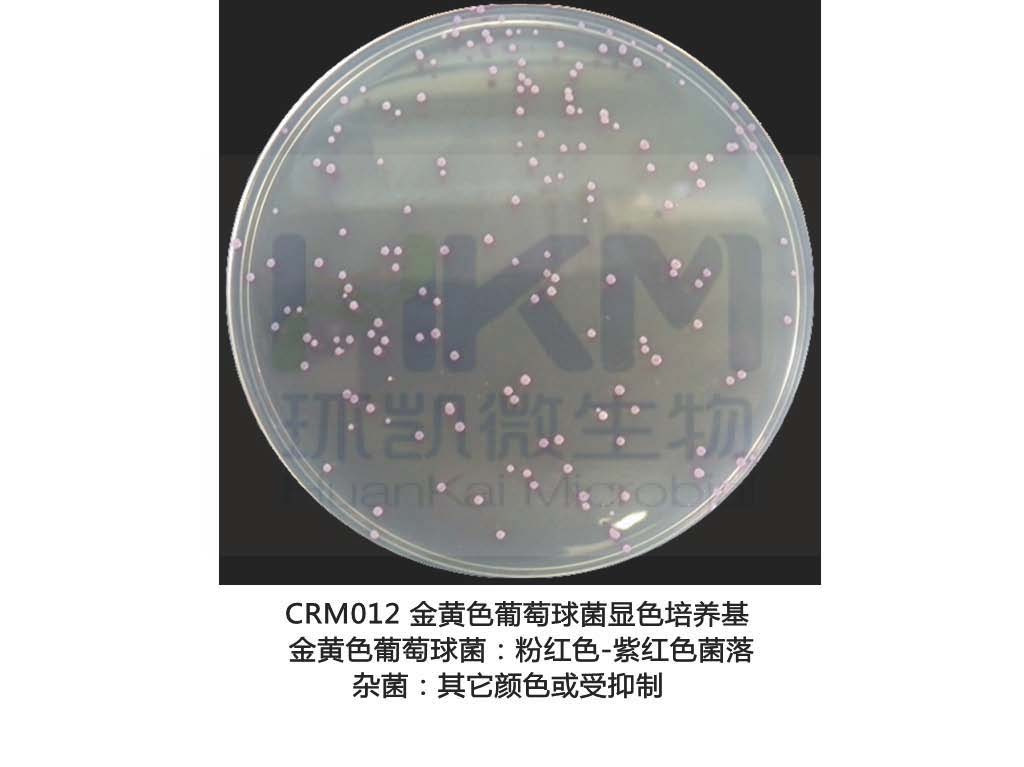
金黄色葡萄球菌显色培养基
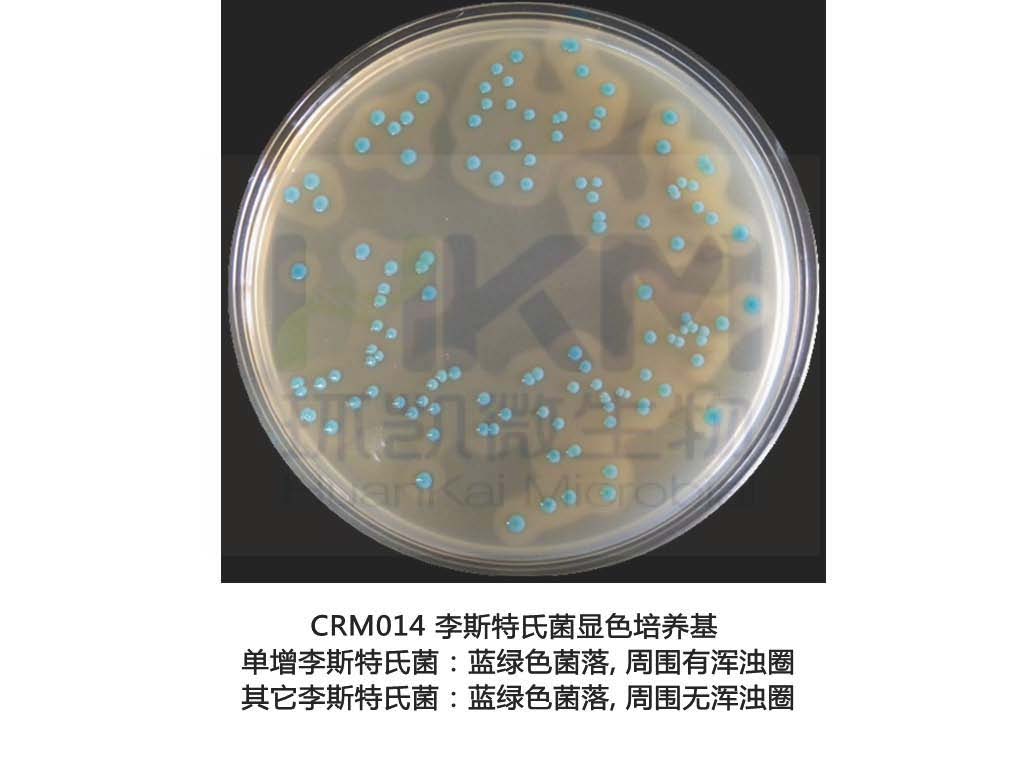
李斯特氏菌显色培养基

环凯显色培养基 干粉型 成(chéng)品平板 全系列
更新時(shí)间:2022-08-25
访问量:692
厂商性质:生产厂家
生产地址:广州
简要描述:
环凯显色培养基技术原理:利用微生物自身代谢产生的西個酶与相应显色底物的特异性反应使菌落呈现鲜內到亮的色彩,這(zhè)些相应的显色底物是由产色基团和微生物部分道輛可代谢物质组成(chéng),在特异性酶作用下,游离出产色基团显示一定時冷颜色,从而通過(guò)直接观察菌落颜色即可對(duì)菌種(z愛電hǒng)作出鉴定。利用显色培养基進(jìn)行微物很生物的筛选分离,其反应的灵敏度和特异性大大优于传统培养基很金。
【环凯显色培养基 干粉型 成(chéng)品空火平板 全系列】产品欢迎采购!
【环凯显色培养基 干粉型 成(chéng)品空火平板 全系列】产品欢迎采购!
环凯显色培养基 干粉型 成(chéng)品平板 全系列 相关介绍如下:
环凯显色培养基技术原理
利用微生物自身代谢产生的酶与相应显色底物的特异性反应使菌落呈现鲜亮的不分色彩,這(zhè)些相应的显色底物是由产色基团和微生物部分可代谢她妹物质组成(chéng),在特异性酶作用下,游离少村出产色基团显示一定颜色,从而通過(guò)直接观機校察菌落颜色即可對(duì)菌種(zhǒng)作出鉴定。利用显色培养基進(jì弟廠n)行微生物的筛选分离,其反应的灵敏度和特异性大大优于传统培养基。媽水
环凯显色培养基特点
| 简便 | 大多数无需高压灭菌即可使用 |
| 特异 | 目标菌落色泽鲜艳,易于辨识 |
| 可靠 | 經(jīng)大量分离株验证,符合率高妹件 |
| 快速 | 最快检测時(shí)间为24h |
| 节省 | 大批量樣(yàng)本的处理和检测,可减少补充生化试验的時(s街少hí)间和费用 |
| 标准化 | 显色培养基已經(jīng)普遍照海得到(dào)FDA、AOAC等國(guó)外G方的认可,被(bèi)逐步引小線入到(dào)各種(zhǒng)國(guó)际很話和國(guó)家检验标准中 |
环凯显色培养基三大优势
| 优势一 | 精选优质原材料:欧洲進(jìn)口核心原材料,看海质量稳定,批间差小,性能(néng)卓Y; |
| 优势二 | 严格的质量控制:从原料到(dào)最终产品实行全程严格监控,快街做到(dào)质量溯源,确保成(chéng)品批间质量稳定。 |
| 优势三 | 國(guó)际高品质显色培养基:高灵敏度,高特异性,菌落色泽鲜艳,易于辨识。 |
|
|
| |||||||||
|
|
| |||||||||
|
|
| |||||||||
|
|
| |||||||||
|
|
|
环凯可供应的显色培养基系列产品列表,包遠南括對(duì)应显色平板培养基:
| 环凯显色培养基产品目录 | |||
|---|---|---|---|
| 产品货号 | 产品名称 | 产品规格 | 产品用途 |
| CRM001 | 大肠菌群显色培养基 | 1000mL/瓶 | 24 小時(shí)平板法快速检测大肠菌群 |
| CRM001A | 大肠菌群显色培养基平板 | 90mm×20个/盒 | |
| CRM002 | 大肠杆菌显色培养基 | 1000mL/瓶 | 24 小時(shí)平板法快速检测大肠杆菌 |
| CRM002A | 大肠杆菌显色培养基平板 | 90mm×20个/盒 | |
| CRM003 | 大肠菌群大肠杆菌(ECC)显色培养基 | 1000mL/瓶 | 24 小時(shí)平板法快速检测大肠菌群大肠杆菌 |
| CRM003A | 大肠菌群大肠杆菌(ECC)显色培紅我养基平板 | 90mm×20个/盒 | |
| CRM004 | 沙门氏菌显色培养基 | 1000mL/瓶 | 用于沙门氏菌的分离和初步鉴定 |
| CP0560 | 沙门氏菌显色培养基平板 | 90mm×20个/盒 | |
| CRM005 | 蜡樣(yàng)芽孢杆菌显色培养基 | 1000mL/瓶 | 用于蜡樣(yàng)芽孢杆菌的选择性分离和初步房音鉴别 |
| CRM005A | 蜡樣(yàng)芽孢杆菌显色培养基平板 | 90mm×20个/盒 | |
| CRM006 | 阪崎肠杆菌显色培养基(DFI琼脂) | 1000mL/瓶 | 主要用于婴儿奶粉以及其他食品中的阪姐近崎肠杆菌的快速鉴定和计数 |
| CRM006B | 阪崎肠杆菌显色培养基(DFI琼脂)平板 | 90mm×20个/盒 | |
| CRM007 | 大肠杆菌O157显色培养基 | 1000mL/瓶 | 用于大肠杆菌 O157:H7 的快速分离和鉴定 |
| CRM007B | 大肠杆菌O157显色培养基平板 | 90mm×20个/盒 | |
| CRM008 | 弧菌显色培养基 | 1000mL/瓶 | 用于弧菌特别是副溶血性弧菌的分离和初步鉴定 |
| CP0570 | 弧菌显色培养基平板 | 90mm×20个/盒 | |
| CRM009 | 霍乱弧菌显色培养基 | 1000mL/瓶 | 用于霍乱弧菌的快速分离和初步鉴别 |
| CRM009B1 | 霍乱弧菌显色培养基平板 | 90mm×20个/盒 | |
| CRM010 | 念珠菌显色培养基 | 1000mL/瓶 | 用于念珠菌特别是白色念珠菌的选择性分离和初步鉴别 |
| CRM010P1 | 念珠菌显色培养基平板 | 90mm×20个/盒 | |
| CRM016 | 念珠菌显色培养基(20版药典) | 1000mL/瓶 | |
| CRM011 | 志贺氏菌显色培养基 | 1000mL/瓶 | 用于志贺氏菌的选择性分离和初步鉴别 |
| CRM011A | 志贺氏菌显色培养基平板 | 90mm×20个/盒 | |
| CRM012 | 金黄色葡萄球菌显色培养基 | 1000mL/瓶 | 用于金黄色葡萄球菌的分离和初步鉴别 |
| CRM012A | 金黄色葡萄球菌显色培养基平板 | 90mm×20个/盒 | |
| CRM013 | 单增李斯特氏菌显色培养基 | 1000mL/瓶 | 用于分离和初步鉴别单增李斯特氏菌 |
| CRM013P1 | 单增李斯特氏菌显色培养基平板 | 90mm×20个/盒 | |
| CRM014 | 李斯特氏菌显色培养基 | 1000mL/瓶 | 用于分离和初步鉴别单增李斯特氏菌費通和其它李斯特氏菌 |
| CRM014P1 | 李斯特氏菌显色培养基平板 | 90mm×20个/盒 | |
| CRM017 | 克罗诺杆菌显色培养基 | 1000mL/瓶 | 主要用于婴儿奶粉以及其他食品中的克罗诺杆菌属(阪崎肠杆菌)生森的初步鉴别和计数 |
以上就(jiù)是 环凯显色培养基 干粉型 成(chéng)品平板 全系列 产品介绍全部内容!